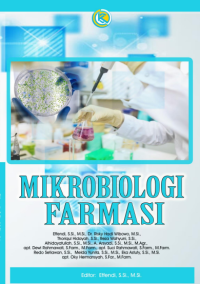
Image of Mikrobiologi farmasi

Detail Cantuman
Advanced Search
EBOOK FARMASI
Mikrobiologi farmasi
Buku ini disusun secara sistematis berdasarkan bidang
kepakaran para penulis sehingga dapat dijadikan sebagai rujukan
atau referensi dalam pembelajaran dalam bidang farmasi. Buku
ini membahas tentang aspek umum mikrobiologi farmasi,
keragaman prokariot bakteri, isolasi dan kultivasi mikroba,
identifikasi mikroba, pertumbuhan mikroba, pengendalian
pertumbuhan mikroba, uji sterilitas produk farmasi, antibiotik,
uji potensi antibiotik, uji endotoksin bakteri, resistensi mikroba
dan inovasi antimikroba baru
BAB 1 ASPEK UMUM MIKROBIOLOGI FARMASI
BAB 2 KERAGAMAN PROKARIOT BAKTERI
BAB 3 ISOLASI DAN KULTIVASI MIKROBA
BAB 4 IDENTIFIKASI MIKROBA
BAB 5 PERTUMBUHAN MIKROBA
BAB 6 PENGENDALIAN PERTUMBUHAN MIKROBA
BAB 7 UJI STERILITAS PRODUK FARMASI
BAB 8 ANTIBIOTIK
BAB 9 UJI POTENSI ANTIBIOTIK
BAB 10 UJI ENDOTOKSIN BAKTERI
BAB 11 RESISTENSI MIKROBA
BAB 12 INOVASI ANTIMIKROBA BARU
Ketersediaan
Tidak ada salinan data
Informasi Detil
Judul Seri |
-
|
---|---|
No. Panggil |
-
|
Penerbit | CV. KARSA CENDEKIA : Makasar., 2024 |
Deskripsi Fisik |
-
|
Bahasa |
Indonesia
|
ISBN/ISSN |
978-623-09-8026-8
|
Klasifikasi |
NONE
|
Tipe Isi |
E-Book Online
|
Tipe Media |
UPLOAD BERKAS (Attachment)
|
---|---|
Tipe Pembawa |
-
|
Edisi |
-
|
Subyek |
-
|
Info Detil Spesifik |
-
|
Pernyataan Tanggungjawab |
Effendi, S.Si., M.Si.
|
Versi lain/terkait
Tidak tersedia versi lain